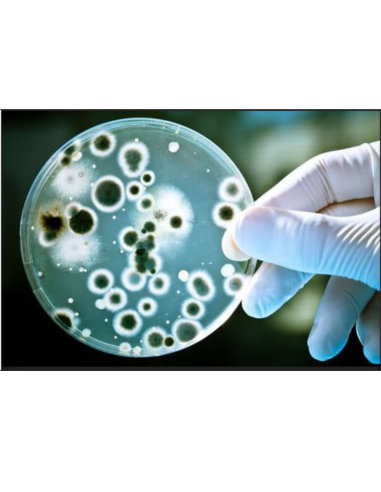
Protettivo Trasparente Antimicrobico Annerimento Muri N.AG PLUS spray 500 ml

- Nuovo
Protettivo Trasparente Antimicrobico Annerimento Muri N.AG PLUS spray 500 ml
Riferimento: 83000329 | Brand: CHIMICA ITALIANA RESTAURI
Disponibilità:
In pronta consegna
Spedizione:
Gratuita
Protettivo antimicrobico in nano-dispersione superfici esterne
- CARATTERISTICHE: protettivo contro il proliferare di microrganismi su pietre, cotto, mattoni faccia a vista e superfici storico-artistiche
- FUNZIONALITA': la sua formula impedisce la formazione di colonie di batteri, muschi, licheni, lieviti e muffe, che possono annerire e deteriorare le superfici
- RISULTATO: superfici protette contro ogni tipo di microrganismo senza alterarne l'aspetto estetico
- CONFEZIONE: flacone spray da 500 ml con resa indicativa di 10-15 m²/litro
- USO: pronto all'uso; applicare il prodotto puro con un pennello morbido in fibre naturali, lasciando assorbire completamente
Scopri la protezione di N.AG PLUS CIR
N.AG PLUS è il protettivo ideale per combattere il proliferare di microrganismi su una vasta gamma di superfici, incluse pietre naturali, cotto, mattoni faccia a vista e persino superfici di interesse storico-artistico e monumentale.
È perfetto per superfici pitturate, tinteggiate e rivestimenti plastici o a cappotto, purché il pH del supporto non superi 7,5. (Evitare l'applicazione su pitture foto-catalitiche).
Proprietà Uniche di N.AG Plus Cir
- N.AG PLUS è una nano-dispersione acquosa a base di argento metallico in forma colloidale (dimensione particellare ≤ 100 nm).
- Questo avanzato protettivo offre una protezione preventiva senza pari contro la crescita e la proliferazione di batteri e microrganismi su superfici esterne.
- La sua formula unica impedisce la formazione di colonie di batteri, muschi, licheni, lieviti e muffe, che possono annerire e deteriorare le superfici.
Vantaggi Principali
- Protezione a Lungo Termine: N.AG PLUS garantisce un'efficacia prolungata nel tempo, grazie alla totale stabilità agli agenti atmosferici, inclusi i raggi UV.
- Non Tossico: sicuro per l'uomo e per l'applicatore, offre una soluzione ecologica e sostenibile rispetto ai tradizionali agenti antibatterici.
- Trasparente e Non Pellicolante: non altera l'aspetto estetico delle superfici trattate, mantenendole visivamente inalterate e piacevoli.
- Ampio Spettro di Azione: efficace contro batteri, muschi, licheni, lieviti e muffe, prevenendo l'annerimento e il biodeterioramento delle superfici architettoniche e monumentali.
Modalità d'Uso
- L'applicazione di N.AG PLUS è semplice, ma richiede attenzione per garantire i migliori risultati.
- Preparazione della Superficie: Se le superfici presentano infestazioni di microrganismi, pulirle preventivamente con detergenti specifici come BIO C.
- Test Preliminare: Prima dell'applicazione, eseguire un test sulla superficie per verificare la compatibilità del prodotto ed evitare l'ossidazione del principio attivo.
- Applicazione: N.AG PLUS è pronto all'uso e non deve essere diluito. Utilizzare strumenti nuovi o perfettamente puliti e asciutti. Applicare il prodotto puro con un pennello morbido in fibre naturali, lasciando assorbire completamente.
- Precauzioni: Evitare il contatto con acqua non demineralizzata, cloro attivo, cloruri, nitrati, solfati e sostanze con pH superiore a 7,5. Non additivare a pitture o vernici.
- Resa Indicativa: Il prodotto copre circa 10-15 m²/litro, variando in base al grado di assorbimento delle superfici trattate.
Perché Scegliere N.AG PLUS di Cir
- Innovazione e Tecnologia: Grazie alla sua formulazione avanzata, N.AG PLUS offre una protezione eccezionale contro i microrganismi.
- Sicurezza e Sostenibilità: Privo di tossicità, è sicuro per l'uso umano e rispetta l'ambiente.
- Facilità d'Uso: La sua formula pronta all'uso e l'applicazione semplice lo rendono ideale sia per professionisti che per appassionati del fai-da-te.
- Effetto Estetico Inalterato: Mantiene l’aspetto naturale delle superfici trattate, senza alterazioni visive.